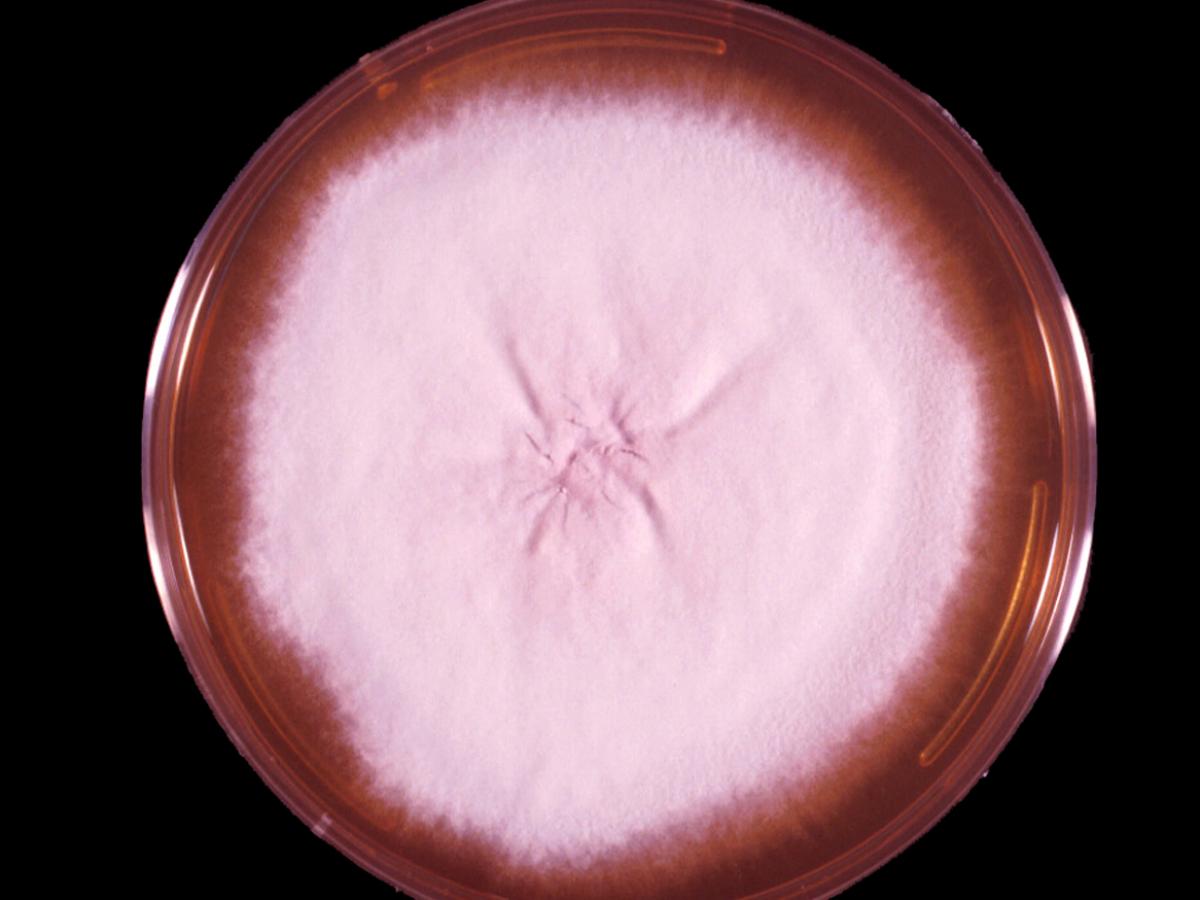
Culture

Unknown 51
Mould identification: a virtual self assessment
Case history
A country veterinarian submitted some skin scrapings taken from the comb of a chicken. The fungus shown below was isolated.

Clinical presentation
Culture

Microscopy